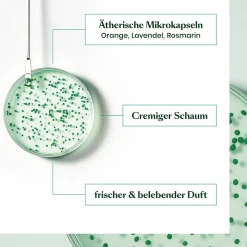
Rene Furterer Forticea Vitalisierendes Shampoo 600 ml

Kräftigt & stärkt das Haar von der Wurzel an
Das Rene Furterer Forticea Vitalisierendes Shampoo ist ein echter Energieschub und Frischekick: Die einzigartige Kombination aus Koffein mit seiner haarwuchsfördernden Wirkung, Guaranasamen-Extrakt , einem kraftvollen natürlichen Energiespender , und anregenden ätherischen Ölen aus Orange, Lavendel und Rosmarin, weckt die Kraft und Vitalität Ihres Haares. Das Haar ist von der Wurzel an gestärkt, wird kräftiger und lässt sich leichter frisieren.
Eigenschaften des Rene Furterer Forticea Vitalisierendes Shampoos
- Stimulierendes Shampoo bei Haarausfall
- Stärkt das Haar bis in die Haarwurzel und beugt Haarausfall vor
- Vitalisiert das Haar
- Verleiht Stärke und Vitalität
- Das Haar fühlt sich nach dem Styling leicht an
- frei von Silikonen
Anwendung des Rene Furterer Forticea Vitalisierendes Shampoos
Das Shampoo auf die feuchte Kopfhaut auftragen, einmassieren und anschließend gründlich ausspülen.
Über Rene Furterer Forticea
Ein echter Energieschub und Frischekick: Die einzigartige Kombination aus Koffein, mit seiner haarwuchsfördernden Wirkung, Guaranasamen-Extrakt, einem kraftvollen natürlichen Energiespender und anregenden ätherischen Ölen aus Orange, Lavendel und Rosmarin, weckt die Kraft und Vitalität Ihres Haares.
Über Rene Furterer
Die Expertenpflege für Haar & Kopfhaut
Als Spezialist für eine individuelle Haar- und Kopfhautpflege bietet Ihnen René Furterer personalisierte Pflegeroutinen, abgestimmt auf Ihre Bedürfnisse. Das Besondere: Die nach- gewiesene Wirkung all ihrer Premium-Haarpflegeprodukte basiert auf Aktivstoffen rein natürlichen Ursprungs. So sind ihre Produkte selbstverständlich silikonfrei und ihre erfolgreichen Rezepturen das Ergebnis aus über 65 Jahren Forschung und Entwicklung. Ihr Know-how hilft ihren Kunden auf der ganzen Welt, mit einem individuellen Pflegeritual ihren Traum von schönem Haar und einer dauerhaft gesunden Kopfhaut wahr werden zu lassen. Entdecken Sie eine ganzheitliche Pflege, die Ihr Haar Tag für Tag verwöhnt und Sie in all Ihren Sinnen verzaubert! Für natürlich gesundes und schönes Haar.
| Menge | 600 ml |
|---|---|
| Marke | Rene Furterer |
| Produkttyp | Shampoo |
| Haartyp | alle Haartypen, dünner werdendes Haar, feines Haar |
| Wirkung | Aktivierend, Kräftigend, Vitalisierend |
| Inhaltsstoffe | WATER (AQUA). LAURYL GLUCOSIDE. SODIUM COCOYL ALANNATE. COCO-BETAINE. AGAR. ALGIN. BENZOIC ACID. CAFFEINE. CALCIUM GLUCONATE. CELLULOSE. CELLULOSE GUM. CHROMIUM HYDROXIDE GREEN (CI 77289). CHROMIUM OXIDE GREENS (CI 77288). CITRIC ACID. CITRUS AURANTIUM DULCUS (ORANGE) OIL. FRAGRANCE (PARFUM). GLUCONOLACTONE. GLYCERIN. GREEN 3 (CI 12053). HYDROCYYPROPYL GUAR HYDROXYPROPYLTRIMONIUM CHLORIDE. LAVANDULA ANGUSTFOLIA (LAVENDER OIL). LIMONENE. LINALOOL. MALTODEXTRIN. METHYL GLUCOSE DIOLEATE. NIACINAMIDE. PANTHENOL. PANTOLACTONE. PAULINA CUPANA SEED EXTRACT. PROPANEDIOL. ROSMARINUNS OFFICINALIS (ROSMARINUS LEAF OIL). SODIUM BENZOATE. TALC. TOCOPHEROL. TOCOPHERYL ACETATE. YELLOW 5 (CI 19142). |
| Kopfhaut | alle Hauttypen |
| Besonderheit | pH-Neutral, Silikonfrei |
| Duftnote | Maskuliner Duft |
| EAN | 3282770389777 |

Reviews
There are no reviews yet.